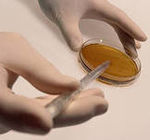

Новости по тегу "проверки"

Помогаем покупателям и продавцам находить друг друга с 2000 года
Omskrielt – это старейший сайт о недвижимости в Омске и Омской области. С нами работают проверенные агентства региона, а также надежные частные риэлторы – они не только размещают свежие объявления и информацию об интересных акциях, но и делятся советами по выбору объектов, проверке продавцов, подготовке документов и рассказывают о других важных нюансах.
Найти подходящий объект среди тысяч объявлений о недвижимости легко – просто воспользуйтесь фильтрами и включите сортировку по цене, дате или площади. Также вы можете оставить заметку для себя или добавить объект в избранное – тогда, когда владелец решит снизить стоимость, мгновенно узнаете об этом. Стараемся сделать сайт максимально удобным.
Если возникнут вопросы, предложения по улучшению сервиса или о сотрудничестве – свяжитесь с нами, отвечаем быстро.
